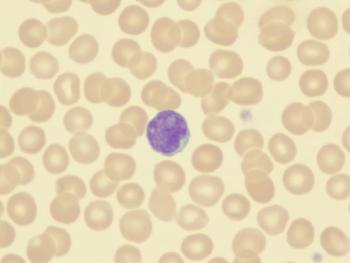

The EGFR inhibitor neratinib may be effective in the treatment of non-small cell lung cancer, according to updated interim findings from the phase 2 SUMMIT trial.

Nicholas Wrigley formerly wrote for CancerNetwork and was an editor for the journal ONCOLOGY.
He is a writer of fiction; his work has appeared in a local anthology, the Best Short Stories of Philadelphia, and elsewhere. He holds an MFA in Creative Writing from Temple University and spends most of his spare time reading books, writing books, playing video games, or sleeping. He has inexplicably strong opinions on East European history, Star Wars, and pasta. He lives in Greater Philadelphia with his family and, more importantly, their two dogs.

The EGFR inhibitor neratinib may be effective in the treatment of non-small cell lung cancer, according to updated interim findings from the phase 2 SUMMIT trial.

The first-in-class Heat Shock Factor 1 pathway inhibitor NXP800, the subject of an ongoing phase 1 dose-escalation study, has been granted a Fast Track designation for the treatment of platinum-resistant ovarian cancer by the FDA.

An expert from NYU Langone in New York City recently discussed the strengths and limitations of the oral tyrosine kinase inhibitor mobocertinib in platinum-pretreated patients with EGFR exon 20 insertion+ metastatic non-small cell lung cancer.
The use of hypomethylating drugs such as azacitidine and decitabine improved outcomes for patients of advanced age with acute myeloid leukemia, according to findings from a recent retrospective study of real-world data.

The allogeneic anti-CD19 CAR-T cell therapy CB-010 has received 2 designations from the FDA, including a fast-track designation for relapsed/refractory B-cell non-Hodgkin lymphoma.

Findings from a recent 30-year analysis of more than 1,000 gynecologic cancer trials strongly suggest that reporting race and ethnicity must be a required part of clinical research to improve diversity, according to a group of researchers.

A longer, 30-month treatment duration with bevacizumab did not improve outcomes over the standard 15-month treatment duration in patients with newly diagnosed ovarian cancer.

Erica C. Nakajima, MD, discussed a pooled analysis analyzing immune checkpoint inhibitors with or without chemotherapy in the frontline treatment of patients with KRAS-mutated non-small cell lung cancer and PD-L1 expression.

Takayuki Yoshino, MD, PhD, spoke about the benefit of panitumumab vs bevacizumab in combination with mFOLFOX6 in the frontline treatment of patients with RAS wild-type metastatic colorectal cancer.

Autologous tumor lysate–loaded dendritic cell vaccine plus standard-of-care therapy improved survival outcomes vs standard-of-care alone in newly diagnosed and recurrent glioblastoma.

Factors such as chemotherapy treatment and a cancer diagnosis within the past 5 years were associated with a greater risk of frailty-related bone fractures among older cancer survivors, according to findings from a recent cohort study.

Pulsatile, convection-enhanced delivery of topotecan using a novel subcutaneous catheter-pump system implanted into the brain showed promising efficacy signals in patients with glioblastoma, according to findings from a phase 1b clinical trial.

Elevated circulating tumor fraction was associated with worsened overall survival across 4 advanced cancer types, according to data from an observational study.

For camidanlumab tesirine to be considered for an accelerated approval path in relapsed/refractory Hodgkin lymphoma, the FDA has strongly recommended conducting confirmatory phase 3 research at the time of biologic license application submission.

For patients with colon cancer, 3-month treatment with mFOLFOX6 or CAPOX improved safety outcomes without affecting efficacy vs 6-month treatment, according to data from the phase 3 ACHIEVE trial.

Higher neighborhood socioeconomic status improves long-term survival in patients with multiple myeloma regardless of overlapping disparities between racial and ethnic groups.

Findings from a secondary analysis highlighted an association between improved quality of life outcomes and longitudinal use of approach-oriented coping strategies in patients with acute myeloid leukemia.

Opioid use disorder and overdose are important risks to consider in older patients diagnosed with stage II/III colorectal cancer, especially those who were opioid naïve.

Atezolizumab plus R-CHOP appeared to yield durable clinical benefit and a safety profile consistent with known toxicities in patients with previously untreated DLBCL, according to data from a phase 1b/2 trial.

Data from the phase 2 FIGHT study indicated that the monoclonal antibody bemarituzumab may be a promising treatment when combined with mFOLFOX6 for patients with advanced gastric or gastro-esophageal junction adenocarcinoma.

Findings from a retrospective cohort study indicated that radiotherapy treatment for breast cancer appeared to be a significant risk factor in developing thoracic soft tissue sarcoma.

The addition of metastasis-directed therapy to intermittent hormone therapy appeared to improve survival in patients with oligometastatic prostate cancer, according to early data from the phase 2 EXTEND trial.

Induction chemotherapy combined with concurrent lobaplatin chemoradiotherapy improved safety outcomes without sacrificing efficacy vs a cisplatin-based regimen in patients with head and neck squamous cell carcinoma.

Results from the UK phase 2 PEACOCC trial found improved outcomes with pembrolizumab monotherapy in patients with previously-treated advanced clear cell gynecological cancers.

Findings from a retrospective cohort study found that immune checkpoint inhibitors induced promising responses in the first- and second-line treatment of head and neck squamous cell carcinoma.

Patients with advanced type B3 thymoma and thymic carcinoma who progressed after chemotherapy were responsive to treatment with avelumab plus axitinib, according to data from the phase 2 CAVEATT trial.

Disease-free survival was not reached with perioperative nor adjuvant chemotherapy with gemcitabine plus nab-paclitaxel in patients with resectable pancreatic cancer, although neoadjuvant chemotherapy yielded a numerical improvement in overall survival, according to data from the phase 2 NEONAX trial.

Many communities face persistent and tenacious issues surrounding the treatment of patients with breast cancer, according to the founder of the Missing Pink Breast Cancer Alliance.

Incorporating tumor grade and histology into an externally validated modified salivary gland staging system improved hazard discrimination in patient subgroups.

Patients with mantle cell lymphoma experienced higher relative risks of respiratory, blood, and infectious disease relative to the general population, regardless of treatment type.